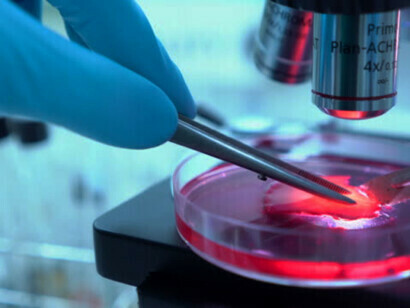
Cientistas fazendo uma pesquisa com células-tronco

Embora as vacinas contra a Covid-19 tenham dominado as manchetes, outras vacinas importantes foram desenvolvidas. Elas têm como alvo a malária, o vírus sincicial respiratório, a fibrose cística, a obesidade, várias doenças metabólicas (incluindo diabetes), a insuficiência cardíaca, a endometriose, o lúpus, a doença inflamatória intestinal, a dermatite atópica e muitos tipos de câncer1-2. Houve até mesmo vacinas que reverteram o envelhecimento em camundongos3-6. Elas removem células perigosas que se tornaram senescentes em vez de morrer. A boa saúde depende, em parte, da decomposição e regeneração contínuas de células, organelas, proteínas e outras partes das células.
Somos organismos complexos, autorregeneradores e autopoiéticos, cujos corpos são ecossistemas que vivem em ecossistemas maiores. A vida é sustentada por uma rede de processos de produção, na qual a função de quase todos os componentes é participar da produção ou transformação de si mesmos e dos outros componentes da rede7-8. Uma visão sistêmica da vida e da saúde incentiva a busca de interações dentro dos sistemas, em vez de reduzir a vida a uma máquina que consiste em componentes separados. Por exemplo, o sistema nervoso, o sistema imunológico e o sistema endócrino não devem ser considerados sistemas independentes. Em vez disso, eles formam um sistema neuroendócrino. Ele inclui não apenas os órgãos tradicionalmente considerados parte do sistema endócrino (como o pâncreas), mas também os ossos, o tecido adiposo, os músculos, os rins e o sistema linfático.
A importância das células-tronco na medicina moderna foi descrita recentemente nesta revista9. As células-tronco reabastecem as células mortas. As células-tronco reparam e mantêm músculos, ossos e nosso sistema imunológico neuroendócrino. Mitocôndrias, ribossomos e outras organelas saudáveis são muito importantes para regular as funções vitais de todas as células. As principais proteínas devem ser quebradas e refeitas quando necessário. Assim como o corpo inteiro precisa manter a homeostase geral, as células dentro dele precisam manter uma rede equilibrada de homeostase proteica (proteostase)10. As proteínas são produzidas em uma organela chamada o ribossomo. As proteínas devem se dobrar em suas estruturas tridimensionais adequadas para manter a saúde. As proteínas mal dobradas podem formar placas que levam a danos oxidativos e doenças como o mal de Alzheimer. As proteínas adequadamente dobradas que controlam o metabolismo celular devem ser degradadas quando não são necessárias. Tanto as proteínas mal dobradas quanto as normais podem ser degradadas por uma organela chamada a proteassoma. A energia necessária para esses e outros processos celulares essenciais é fornecida pelas mitocôndrias. Juntas, elas mantêm uma proteostase saudável. A perda da proteostase e a exaustão das células-tronco são duas das marcas registradas do envelhecimento10. A homeostase das células-tronco é mantida pelo controle da tradução do ARN em proteínas nos ribossomos e pela quebra das proteínas nos proteossomos quando necessário. Há também uma camada de controle acima do ADN (genoma), chamada epigenoma. Ela pode ativar ou desativar a transcrição do ADN em ANR ao anexar ou remover marcadores, como grupos metil. Há também um epitranscriptoma que modifica as proteínas que foram transcritas. Por exemplo, a ligação e a remoção de grupos fosfato nas proteínas podem ativá-las ou inativá-las. O epitranscriptoma, o controle translacional e a degradação de proteínas trabalham juntos para regular os proteomas, que ajudam a controlar a identidade e a função das células-tronco11. O envelhecimento está associado a uma diminuição da capacidade de regeneração dos tecidos e a um aumento da incidência de doenças degenerativas12. Como resultado, a função das células-tronco diminui em muitos tecidos durante o envelhecimento. Isso é especialmente verdadeiro no sangue e no sistema imunológico neuroendócrino.
Ao mesmo tempo, a terapia com células-tronco tem grande potencial na medicina regenerativa13-14. As células-tronco podem ser totipotentes, pluripotentes, multipotentes ou unipotentes. As células totipotentes em um zigoto podem se diferenciar em todos os tipos de células. As células-tronco pluripotentes (CTPs) podem se diferenciar em praticamente qualquer tipo de célula. Elas podem ser células-tronco embrionárias (CTEs) ou células das camadas germinativas (mesoderma, ectoderma e endoderma). As células-tronco multipotentes só podem se diferenciar em células intimamente relacionadas. Por exemplo, as células-tronco hematopoiéticas podem se transformar em glóbulos vermelhos, glóbulos brancos e plaquetas. As células-tronco musculares unipotentes só podem se diferenciar em células musculares. As células-tronco mesenquimais (CTMs) são células-tronco específicas de tecidos que são usadas para reparar tecidos danificados e são úteis na medicina regenerativa. As CTMs podem gerar ossos, cartilagens e outros tipos de tecido. O uso de CTMs não causa problemas éticos em comparação com as CTEs e são menos tumorigênicas do que as CTPs. As vesículas extracelulares das células-tronco também podem ser úteis na medicina regenerativa14-15.
As células-tronco endógenas estão sendo usadas para reparar e regenerar tecidos, inclusive o tecido do cristalino humano nos olhos, que pode ser danificado pela catarata13. Elas são a principal causa de cegueira em todo o mundo. Até recentemente, o único tratamento para a catarata era extrair a lente catarata e implantar uma lente intraocular artificial. No entanto, esse procedimento pode causar complicações. Assim, os pesquisadores criaram um método cirúrgico para remover a catarata e preservar as células-tronco endógenas do paciente. Eles regeneraram lentes funcionais em coelhos e macacos, bem como em bebês humanos.
Outra abordagem é proteger as células-tronco dos danos oxidativos causados por células senescentes que deveriam ter morrido quando pararam de se dividir, mas não morreram. Há um limite para o número de vezes que as células humanas podem se dividir. Em 1961, Leonard Hayflick e Paul Moorhead descobriram esse limite estudando linhas celulares de fibroblastos diploides, que não se dividiam após 40-60 divisões celulares16. Após cerca de 50 divisões celulares, deve ocorrer a morte celular programada17. Entretanto, algumas células podem se tornar senescentes. Elas entram em um estado de parada do ciclo celular em resposta a estímulos prejudiciais. As células senescentes aparecem durante toda a vida humana. Elas podem persistir e danificar os tecidos devido às muitas proteínas que secretam.
A senescência pode ser protetora em alguns momentos e prejudicial em outros18. O papel da senescência celular em pessoas mais jovens é reparar e curar feridas. As células danificadas e senescentes são removidas pelo sistema imunológico. A senescência é uma estratégia de proteção evolutiva. Após danos não letais ao ADN, uma célula pode se tornar senescente. Isso impede que ela sofra uma transformação maligna. Entretanto, à medida que a maioria das pessoas envelhece, o sistema imunológico não consegue remover todas as células senescentes. Eventualmente, o acúmulo de mais células senescentes pode ajudar a causar várias doenças do envelhecimento. Apesar da interrupção do crescimento, as células senescentes continuam a influenciar o ambiente ao seu redor. Elas produzem e secretam muitas citocinas e sinais pró-inflamatórios. Isso é conhecido como SASP (Senescence-Associated Secretory Phenotype, Fenótipo secretor associado à senescência). Isso leva a uma inflamação latente, que pode causar danos sistêmicos e doenças generalizadas. É necessário um equilíbrio entre a oxidação e a redução (homeostase redox) para manter a capacidade das células-tronco de se autorrenovarem e se diferenciarem, evitando a senescência19. Quando a homeostase redox é perturbada pelo estresse oxidativo, as células-tronco podem perder algumas propriedades importantes e se tornar senescentes ou até mesmo malignas.
Existem alguns compostos senolíticos que podem eliminar as células senescentes e os danos que elas podem causar. Isso inclui o dasatinibe, que foi aprovado pelo Administração de Alimentos e Medicamentos dos EUA (Food and Drug Administration, FDA) e usado extensivamente desde 2006. Ele tem um perfil de segurança muito bom. Os flavonoides naturais quercetina e fisetina também são senolíticos. Eles estão amplamente disponíveis como suplementos dietéticos.
Outros pesquisadores estão desenvolvendo vacinas que têm como alvo e removem as células senescentes5-6. Assim como outras vacinas que têm como alvo proteínas específicas produzidas por vírus, elas têm como alvo proteínas na superfície das células senescentes. Uma delas retardou a progressão da fragilidade em camundongos idosos. A vacina teve como alvo as células senescentes no tecido adiposo e nos vasos sanguíneos. Portanto, ela poderia ter um impacto positivo em outras condições médicas ligadas ao envelhecimento, como o enrijecimento arterial e o diabetes.
Portanto, a terapia com células-tronco, os senolíticos e as vacinas antienvelhecimento estão entre as ferramentas que podem ser usadas para retardar, prevenir e, esperamos, um dia até reverter o envelhecimento. Conforme descrito anteriormente neste periódico, uma combinação de hormônio de crescimento humano recombinante, o suplemento dietético dehidroepiandrosterona e o medicamento de prescrição metformina aparentemente foi capaz de reverter o envelhecimento e o desenvolvimento da senescência nos sistemas imunológicos neuroendócrinos em pessoas que participaram de um estudo clínico20. Mais trabalhos estão sendo feitos sobre essa e outras abordagens.
Bibliografia
1 Smith, R.E. Malaria vaccine is effective in children. How malaria is very different than Covid-19. Meer, 24 May, 2021.
2 Smith, R.E. New vaccines for Covid-19, influenza (flu) and syncytial virus, RSV. Meer, 24 Oct., 2022.
3 Suda, M. Senolytic vaccination improves normal and pathological age-related phenotypes and increases lifespan in progeroid mice. Nature Aging, Vol. 1, pp. 1117-1126, 2021.
4 Lear, T.B.; Finkel, T. Senolytic vaccination: a new mandate for cardiovascular health? Journal of Cardiovascular Aging, Vol. 2, 17. 2022.
5 Nakagami, H.; Yoshida, S.; Morishita, R.; Rakugi, H. CD153 vaccine is a novel senotherapeutic option for removing senescence-associated T cells. 2021, 39, artigo e286.
6 Yoshida, S.; Nakagami, H.; Hayashi, H. et al. The CD153 vaccine is a senotherapeutic option for preventing the accumulation of senescent T cells in mice. Nature Communications, Vol. 11, artigo 2482, 2020.
7 Capra, F and Luisi, P.L. [A Systems View of Life: A Unifying Vision]. Cambridge University Press, Cambridge, UK, 2014.
8 Luisi, P.L. The quest for wholeness. The systems view and the search for spirituality. Meer, 23 May, 2017.
9 Wynne, S. Stem cells. Are they the future of modern science? Meer, 1 Dec., 2022.
10 Chua, B.A. & Signer, R.A.J. Hematopoietic stem cell regulation by the proteostasis network. Current Opinion Hematology, Vol. 27, p. 254–263, 2020.
11 Chua, B.A.; ven der Werf, I.; Janieson, C.; Signer, R.A.J. Post-transcriptional regulation of homeostatic, stressed, and malignant stem cells. Cell Stem Cell 2020, 26, 138-159.
12 Signer, R.A.J.; Morrison, S.J. Mechanisms that regulate stem cell aging and life span. Cell Stem Cell 2013, 12, 152-165.
13 Signer, R.A.J. Lens regeneration using endogenous stem cells with gain of visual function. Nature, 2016, 531, 323–328.
14 Song, B-W. et al. Multiplexed targeting of microRNA in stem cell-derived extracellular vesicles for regenerative medicine. BMB Reports, Vol. 55, p. 65-71, 2022.
15 Jarrige, M. et al. The future of regenerative medicine: cell therapy using pluripotent stem cells and acellular therapies based on extracellular vesicles. Cell, Vol. 10, artigo 240, 2021.
16 Hayfick, L. & Moorhead, P. S. The serial cultivation of human diploid cell strains. Experimental Cell Research, Vol. 25, p. 585–621, 1961.
17 Chaib, S.; Tchkonia, T.; Kirkland, J.L. Cellular senescence and senolytics: the path to the clinic. Nature Medicine, Vol. 28, p. 1556-1568, 2022.
18 Lear, T.B.; Finkel, T. Senolytic vaccination: a new mandate for cardiovascular health? J. cardiovasc. Aging Vol. 2, artigo 17, 2022.
19 Yuan, H. Role of Nrf2 in cell senescence regulation. Molecular and Cellular Biochemistry, Vol. 476, pp. 247-259, 2021.
20 Smith, R.E. Can aging be reversed? Science is a process of continuous improvement. Meer, 24 Dec., 2019.